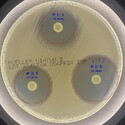

for Antimicrobial Susceptibility Testing in Veterinary Microbiology
– Automating Zone of Inhibition Measurement to Streamline and Standardize AST Workflows –
CarbGeM Inc. (Headquarters: Shibuya-ku, Tokyo, CEO: Masakazu Nakajima, hereinafter “CarbGeM”) has announced the launch of ZOI VET (Zone of Inhibition for Veterinary Medicine), a research-use-only application that automates and standardizes antimicrobial susceptibility testing (AST) in veterinary microbiology.
ZOI VET, which is integrated with a cloud-based AI image analysis digital platform, automatically detects and measures inhibition zones (Zone of Inhibition, ZOI) from Petri dish images. By entering the bacterial species, host animal, and antimicrobial agent, the app instantly provides susceptibility classification—Sensitive, Intermediate, or Resistant (S/I/R)—based on the CLSI VET01S ED7:2024 performance standard.
This application is intended exclusively for research use (RUO) in veterinary and research laboratory settings.
ZOI VET – Zone of Inhibition – measurement
※Please see the image below this article.
_______________________________________
About ZOI VET
Background
Inhibition zone measurements have traditionally been performed manually, relying on visual inspection. This process is not only time-consuming but also prone to human error and variability in interpretation. In response to these challenges, CarbGeM developed ZOI VET to automate AST through AI and provide standardized evaluations aligned with international guidelines.
________________________________________
Key Features
Automated Zone Measurement
AI detects and measures ZOI diameters directly from Petri dish images, enabling fast and high-precision zone analysis.
International Standards-Based Interpretation
The app provides real-time S/I/R classification in accordance with CLSI VET01S ED7:2024. It is regularly updated to reflect the latest veterinary AST guidelines.
Flexible Image Input and Manual Adjustment
Users can easily upload images from smartphones or PCs. Manual correction of inhibition zone outlines is available if necessary.
Data Storage and Sharing
All results are saved automatically, enabling efficient tracking and team collaboration.
Cloud-Based Platform
The web-based interface allows seamless use across laboratories, academic institutions, and remote environments.
[Learn more about ZOI VET]
URL: (リンク »)
________________________________________
Use Cases
• Clinical Support
Veterinarians and laboratory technicians can quickly assess resistance profiles, which support treatment decision-making.
• Microbiology Research
Facilitates data collection and analysis across various antibiotics and animal species.
• Education and Training
Can be used as a practical training tool for veterinary students and junior lab technicians.
• Laboratory Workflow Optimization
Promotes standardization and reproducibility in AST procedures to improve quality and throughput.
________________________________________
Expected Benefits
• Significant reduction in manual workload and time
• Elimination of interpretation variability and human error
• Improved research reliability through standardized data accumulation
• Contribution to One Health initiatives in combating zoonotic antimicrobial resistance
________________________________________
Future Outlook
CarbGeM will continue to expand the applications of ZOI VET beyond veterinary microbiology to fields such as agriculture, environmental monitoring, and food safety.
The company also aims to develop a multi-dimensional analysis platform by integrating genomic and environmental data to better understand antimicrobial resistance.
Through integration with CarbConnect®, CarbGeM is building an ecosystem that enables precise, collaborative analysis and research. The company remains committed to delivering advanced AI-driven tools that empower researchers and healthcare professionals worldwide.
________________________________________
About CarbGeM Inc.
CarbGeM Inc. is dedicated to improving diagnostics, research efficiency, and quality control through automation and AI in the life sciences sector. By addressing challenges such as technician shortages and regional disparities, the company provides tools that enable fast and accurate results in medical and industrial settings.
Through the development of digital platforms and open innovation with domestic and international research institutions, CarbGeM aims to contribute to the global fight against antimicrobial resistance and other critical health challenges.
The company is also engaged in cross-sector collaboration to shape the future of science and medicine.
• Location: 6F, Route Jinnan Building, 1-5-13 Jinnan, Shibuya-ku, Tokyo
• CEO: Masakazu Nakajima
• URL: (リンク »)
ZOI VET, which is integrated with a cloud-based AI image analysis digital platform, automatically detects and measures inhibition zones (Zone of Inhibition, ZOI) from Petri dish images. By entering the bacterial species, host animal, and antimicrobial agent, the app instantly provides susceptibility classification—Sensitive, Intermediate, or Resistant (S/I/R)—based on the CLSI VET01S ED7:2024 performance standard.
This application is intended exclusively for research use (RUO) in veterinary and research laboratory settings.
ZOI VET – Zone of Inhibition – measurement
※Please see the image below this article.
_______________________________________
About ZOI VET
Background
Inhibition zone measurements have traditionally been performed manually, relying on visual inspection. This process is not only time-consuming but also prone to human error and variability in interpretation. In response to these challenges, CarbGeM developed ZOI VET to automate AST through AI and provide standardized evaluations aligned with international guidelines.
________________________________________
Key Features
Automated Zone Measurement
AI detects and measures ZOI diameters directly from Petri dish images, enabling fast and high-precision zone analysis.
International Standards-Based Interpretation
The app provides real-time S/I/R classification in accordance with CLSI VET01S ED7:2024. It is regularly updated to reflect the latest veterinary AST guidelines.
Flexible Image Input and Manual Adjustment
Users can easily upload images from smartphones or PCs. Manual correction of inhibition zone outlines is available if necessary.
Data Storage and Sharing
All results are saved automatically, enabling efficient tracking and team collaboration.
Cloud-Based Platform
The web-based interface allows seamless use across laboratories, academic institutions, and remote environments.
[Learn more about ZOI VET]
URL: (リンク »)
________________________________________
Use Cases
• Clinical Support
Veterinarians and laboratory technicians can quickly assess resistance profiles, which support treatment decision-making.
• Microbiology Research
Facilitates data collection and analysis across various antibiotics and animal species.
• Education and Training
Can be used as a practical training tool for veterinary students and junior lab technicians.
• Laboratory Workflow Optimization
Promotes standardization and reproducibility in AST procedures to improve quality and throughput.
________________________________________
Expected Benefits
• Significant reduction in manual workload and time
• Elimination of interpretation variability and human error
• Improved research reliability through standardized data accumulation
• Contribution to One Health initiatives in combating zoonotic antimicrobial resistance
________________________________________
Future Outlook
CarbGeM will continue to expand the applications of ZOI VET beyond veterinary microbiology to fields such as agriculture, environmental monitoring, and food safety.
The company also aims to develop a multi-dimensional analysis platform by integrating genomic and environmental data to better understand antimicrobial resistance.
Through integration with CarbConnect®, CarbGeM is building an ecosystem that enables precise, collaborative analysis and research. The company remains committed to delivering advanced AI-driven tools that empower researchers and healthcare professionals worldwide.
________________________________________
About CarbGeM Inc.
CarbGeM Inc. is dedicated to improving diagnostics, research efficiency, and quality control through automation and AI in the life sciences sector. By addressing challenges such as technician shortages and regional disparities, the company provides tools that enable fast and accurate results in medical and industrial settings.
Through the development of digital platforms and open innovation with domestic and international research institutions, CarbGeM aims to contribute to the global fight against antimicrobial resistance and other critical health challenges.
The company is also engaged in cross-sector collaboration to shape the future of science and medicine.
• Location: 6F, Route Jinnan Building, 1-5-13 Jinnan, Shibuya-ku, Tokyo
• CEO: Masakazu Nakajima
• URL: (リンク »)
このプレスリリースの付帯情報
本プレスリリースは発表元企業よりご投稿いただいた情報を掲載しております。
お問い合わせにつきましては発表元企業までお願いいたします。
お問い合わせにつきましては発表元企業までお願いいたします。
ZOI VET – Zone of Inhibition – measurement
ZOI VET – Zone of Inhibition – measurement 